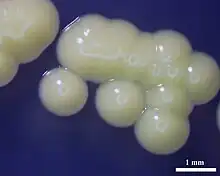

Micrococcus luteus
Micrococcus luteus is a Gram-positive to Gram-variable, nonmotile, tetrad-arranging, pigmented, saprotrophic coccus bacterium in the family Micrococcaceae.[1] It is urease and catalase positive. An obligate aerobe, M. luteus is found in soil, dust, water and air, and as part of the normal microbiota of the mammalian skin. The bacterium also colonizes the human mouth, mucosae, oropharynx and upper respiratory tract.
| Micrococcus luteus | |
|---|---|
![]() | |
| Scientific classification | |
| Domain: | Bacteria |
| Phylum: | Actinomycetota |
| Class: | Actinomycetia |
| Order: | Micrococcales |
| Family: | Micrococcaceae |
| Genus: | Micrococcus |
| Species: | M. luteus |
| Binomial name | |
| Micrococcus luteus (Schroeter 1872) Cohn 1872 | |
Micrococcus luteus is generally harmless but can become an opportunistic pathogen in immunocompromised people or those with indwelling catheters.[2] It resists antibiotic treatment by slowing of major metabolic processes and induction of unique genes. Its genome has a high G + C content.
Micrococcus luteus is coagulase negative, bacitracin susceptible, and forms bright yellow colonies on nutrient agar.
Micrococcus luteus has been shown to survive in oligotrophic environments for extended periods of time. It has survived for at least 34,000 to 170,000 years, as assessed by 16S rRNA analysis, and possibly much longer.[3] Its genome was sequenced in 2010 and is one of the smallest genomes of free-living Actinomycetota sequenced to date, comprising a single circular chromosome of 2,501,097 bp.[4]
Novel codon usage
Micrococcus luteus was one of the early examples of novel codon usage,[5][6] which led to the conclusion that the genetic code is not static, but evolves.
Classification
Micrococcus luteus was formerly known as Micrococcus lysodeikticus.[7]
In 2003, it was proposed that one strain of Micrococcus luteus, ATCC 9341, be reclassified as Kocuria rhizophila.[8]
Ultraviolet absorption
Norwegian researchers in 2013 found a M. luteus strain that synthesizes a pigment that absorbs wavelengths of light from 350 to 475 nanometers. Exposure to these wavelengths of ultraviolet light has been correlated with an increased incidence of skin cancer, and scientists believe this pigment can be used to make a sunscreen that can protect against ultraviolet light.[9]
Tests for identification[10][11][12]
| Test | Result |
|---|---|
| Gram stain | Positive |
| Catalase | Positive |
| Acid from glucose | Negative (yellow pigment) |
| Bacitracin | Sensitive |
| Motility | Negative |
| Nitrate reduction | Negative |
| Urease | Positive |
References
- Madigan M; Martinko J, eds. (2005). Brock Biology of Microorganisms (11th ed.). Prentice Hall. ISBN 978-0-13-144329-7.
- Canada, Public Health Agency of (19 April 2011). "Pathogen Safety Data Sheets: Infectious Substances – Micrococcus spp". www.canada.ca. Retrieved 5 January 2023.
- Greenblatt, C.L.; Baum, J.; Klein, B.Y.; Nachshon, S.; Koltunov, V.; Cano, R.J. (2004). "Micrococcus luteus – Survival in Amber". Microbial Ecology. 48 (1): 120–127. doi:10.1007/s00248-003-2016-5. PMID 15164240. S2CID 24070772.
- Young M, Artsatbanov V, Beller HR, Chandra G, Chater KF, Dover LG, Goh EB, Kahan T, Kaprelyants AS, Kyrpides N, Lapidus A, Lowry SR, Lykidis A, Mahillon J, Markowitz V, Mavromatis K, Mukamolova GV, Oren A, Rokem JS, Smith MC, Young DI, Greenblatt CL (2010). "Genome sequence of the Fleming strain of Micrococcus luteus, a simple free-living actinobacterium". Journal of Bacteriology. 192 (3): 841–860. doi:10.1128/JB.01254-09. PMC 2812450. PMID 19948807.
- Ohama, T; Muto, A; Osawa, S (November 1989). "Spectinomycin operon of Micrococcus luteus: evolutionary implications of organization and novel codon usage". J Mol Evol. 29 (5): 381–395. doi:10.1007/bf02602908. PMID 2533272. S2CID 20770949.
- Ohama, T; Muto, A; Osawa, S (1990). "Role of GC-biased mutation pressure on synonymous codon choice in Micrococcus luteus, a bacterium with a high genomic GC-content". Nucleic Acids Res. 18 (6): 1565–1569. doi:10.1093/nar/18.6.1565. PMC 330526. PMID 2326195.
- Benecky M. J.; Frew J. E.; Scowen N; Jones P, Hoffman B. M (1993). "EPR and ENDOR detection of compound I from Micrococcus lysodeikticus catalase". Biochemistry. 32 (44): 11929–11933
- Tang, Jane. "Reclassification of ATCC 9341 from Microccus luteus to Kocuria rhizophila" (PDF). Retrieved 2 March 2011.
- SINTEF. "Super sunscreen from fjord bacteria." ScienceDaily. ScienceDaily, 6 August 2013.
- Smith, K.J.R.; Neafie, J. Yeager; Skelton, H.G (1999). "Micrococcus folliculitis in HIV-1 disease". British Journal of Dermatology. 141 (3): 558–561. doi:10.1046/j.1365-2133.1999.03060.x. PMID 10583069. S2CID 24976099 – via British Association of Dermatologists.
- M, Madigan; Martinko, J (2005). Brock Biology of Microorganisms. Prentice Hall.
- Bacterial Identification. 1997. pp. 53–56.
{{cite book}}:|work=ignored (help)
External links
Media related to Micrococcus luteus at Wikimedia Commons- MicrobeWiki
- Type strain of Micrococcus luteus at BacDive - the Bacterial Diversity Metadatabase
